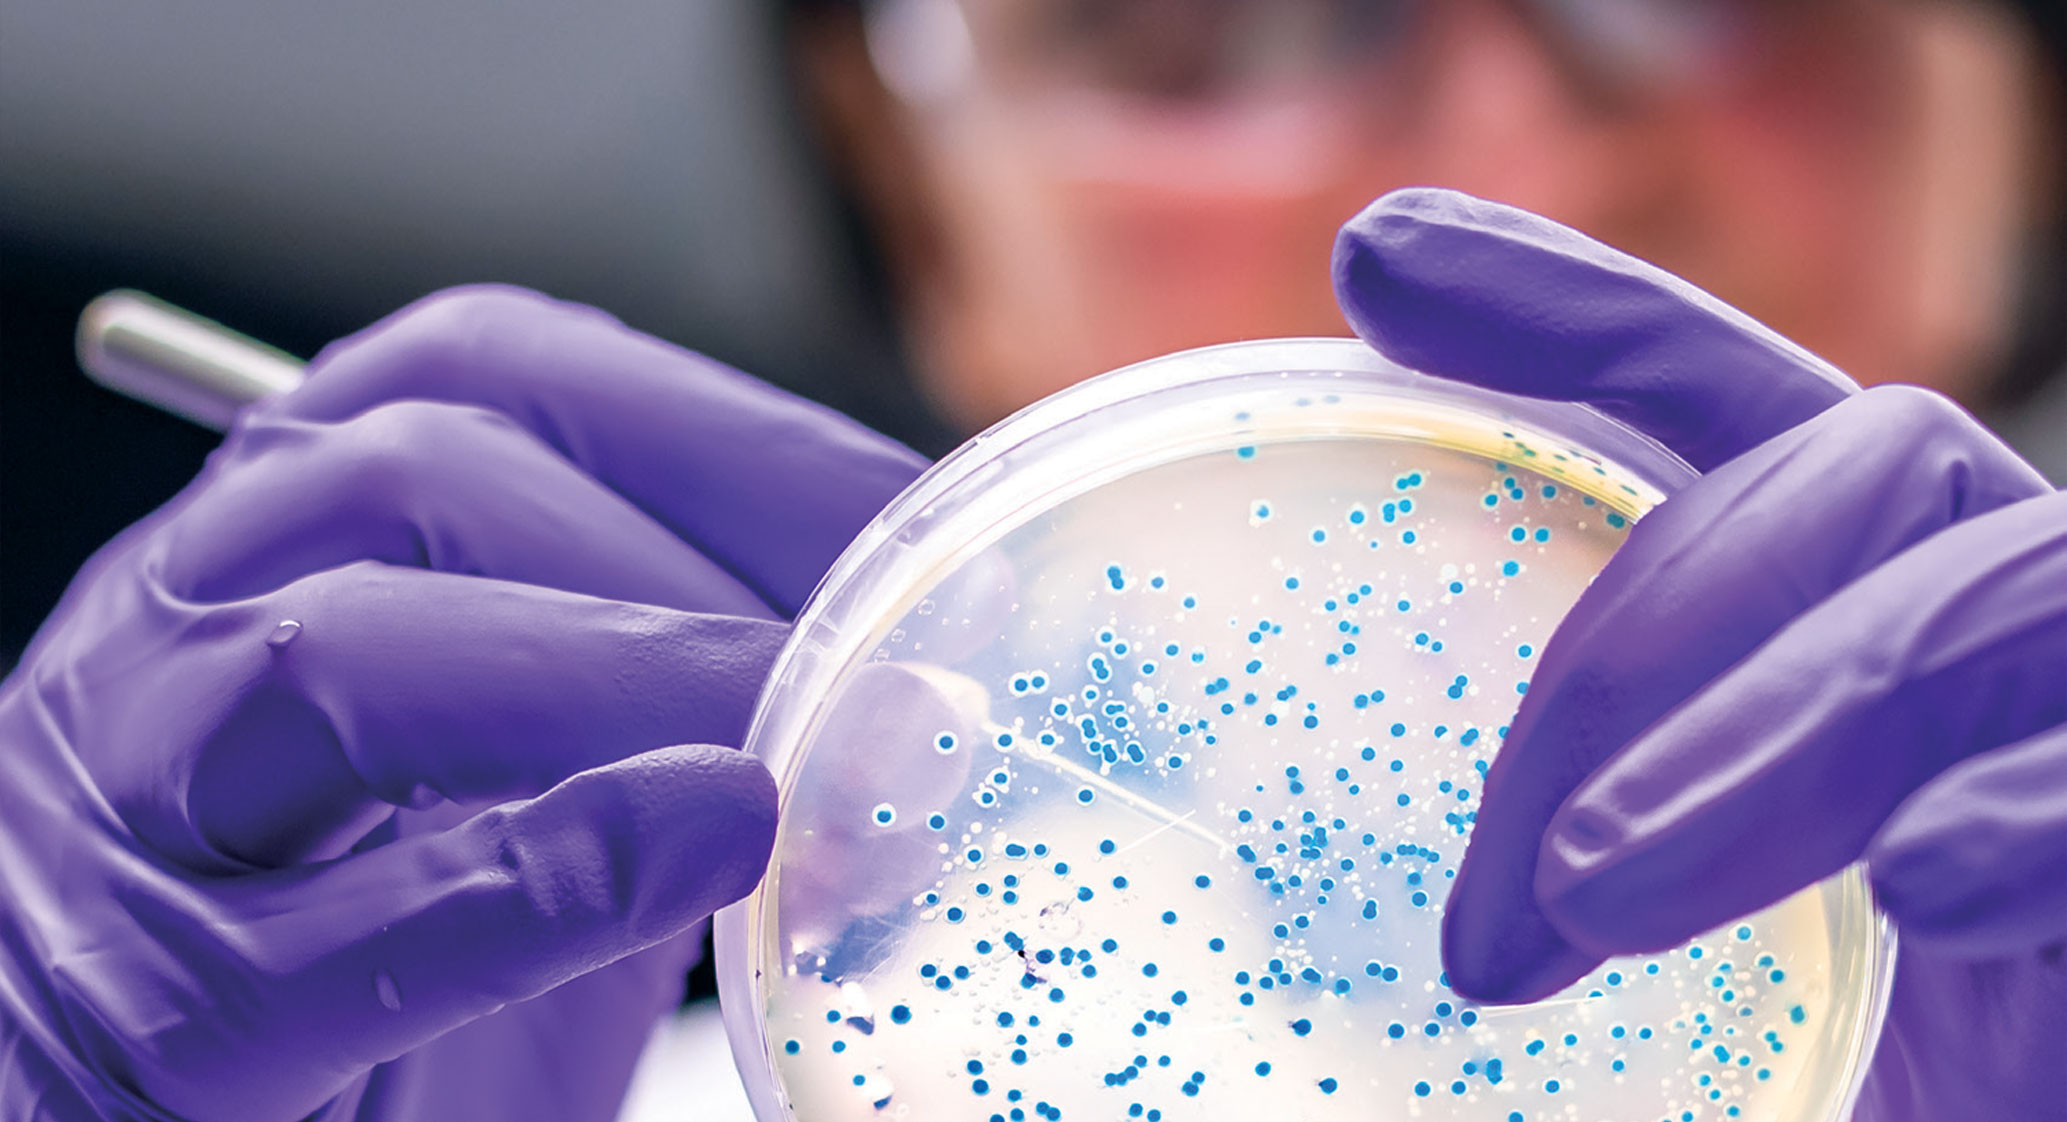
Scientist looking at growth in a petri dish
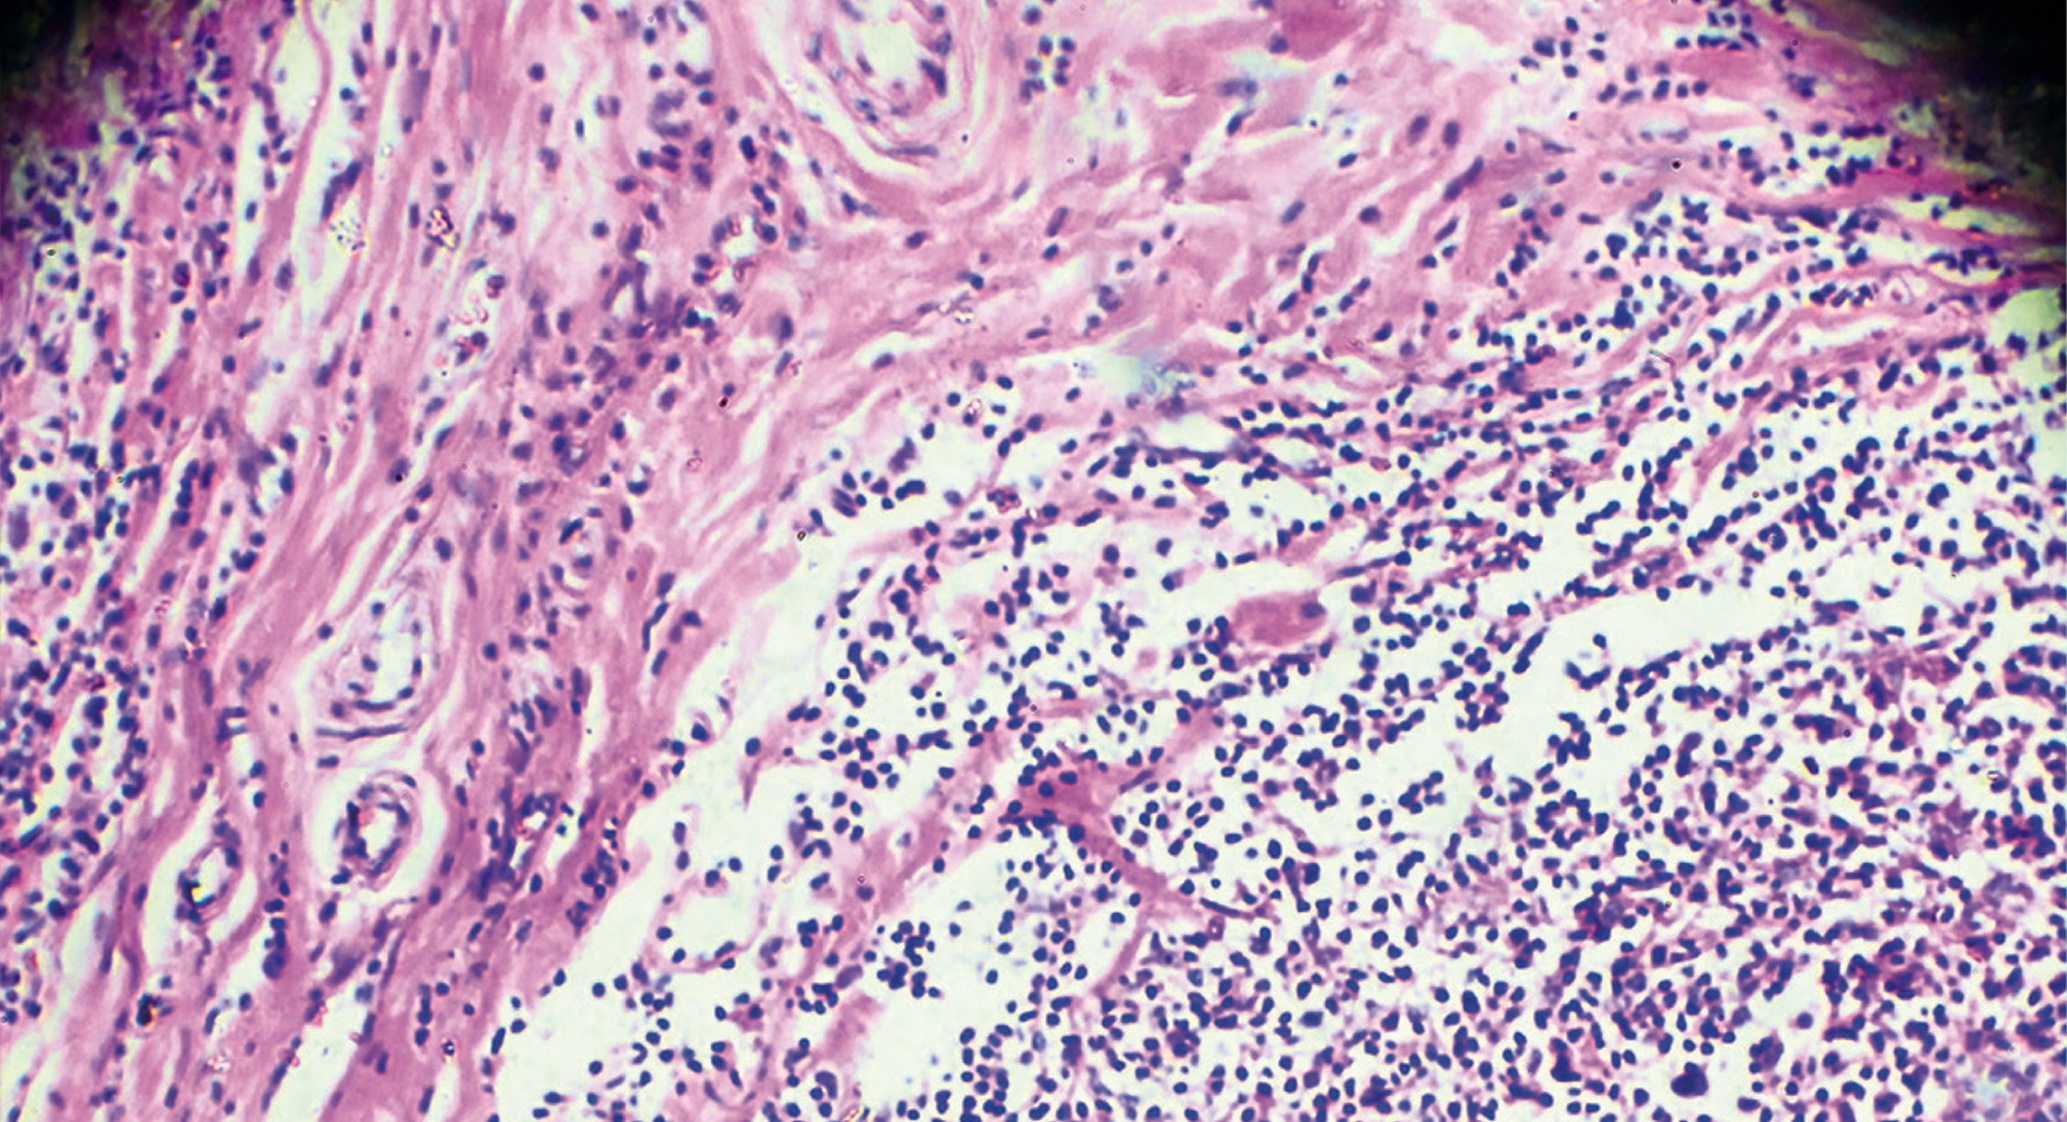
Microscopic view of Hodgkin lymphoma shows closely packed granules with a few patches and strands in-between

At Sylvester, we are dedicated to supporting our patients in their cancer journey and beyond. We do this through research, education, prevention and the delivery of quality patient care. Every year, we are heartened to see the impact of our progress thanks to our physicians, researchers and staff, and the unwavering support of our generous donors. Our annual report presents the highlights of the year, including patients´ inspiring stories, latest research, advocacy and outreach efforts. Join us in our relentless pursuit of a cancer-free future.